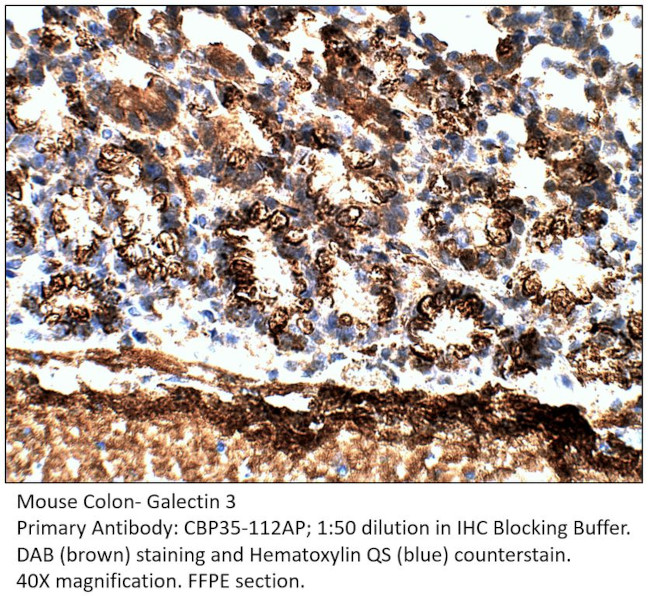
Galectin 3 Antibody in Immunohistochemistry (IHC)

Search
Fabgennix
Galectin 3 Polyclonal Antibody
{{$productOrderCtrl.translations['antibody.pdp.commerceCard.promotion.promotions']}}
{{$productOrderCtrl.translations['antibody.pdp.commerceCard.promotion.viewpromo']}}
{{$productOrderCtrl.translations['antibody.pdp.commerceCard.promotion.promocode']}}: {{promo.promoCode}} {{promo.promoTitle}} {{promo.promoDescription}}. {{$productOrderCtrl.translations['antibody.pdp.commerceCard.promotion.learnmore']}}

Please note: We are reviewing Western blot images included in the antibody testing data in our catalog, including those provided by third parties. Unless expressly labeled or annotated as “raw-unedited”, Western blot images included in the antibody testing data in our catalog may have been edited, optimized or otherwise adjusted for presentation.
产品信息
CBP35-112AP
种属反应
宿主/亚型
分类
类型
抗原
偶联物
形式
浓度
纯化类型
保存液
内含物
保存条件
运输条件
靶标信息
Galactose-specific lectin which binds IgE. May mediate with the alpha-3, beta-1 integrin the stimulation by CSPG4 of endothelial cells migration. Together with DMBT1, required for terminal differentiation of columnar epithelial cells during early embryogenesis. In the nucleus: acts as a pre-mRNA splicing factor. Involved in acute inflammatory responses including neutrophil activation and adhesion, chemoattraction of monocytes macrophages, opsonization of apoptotic neutrophils, and activation of mast cells.
仅用于科研。不用于诊断过程。未经明确授权不得转售。
篇参考文献 (0)
生物信息学
蛋白别名: 35 kDa lectin; Carbohydrate-binding protein 35; CBP 35; CBP-30; epsilon BP; Gal-3; Galactose-specific lectin 3; Galactoside-binding protein; GALBP; Galectin-3; Galectin3; IgE binding protein; IgE-binding protein; L-29; L-31; L-34 galactoside-binding lectin; Laminin-binding protein; lectin galactoside-binding soluble 3 protein; Lectin L-29; lectin, galactose binding, soluble 3; Mac-2 antigen
基因别名: AGE-R3; CBP30; gal-3; gal3; GBP; L-34; LGALS3; Mac-2; MAC2
UniProt ID: (Rat) P08699
Entrez Gene ID: (Mouse) 16854, (Rat) 83781